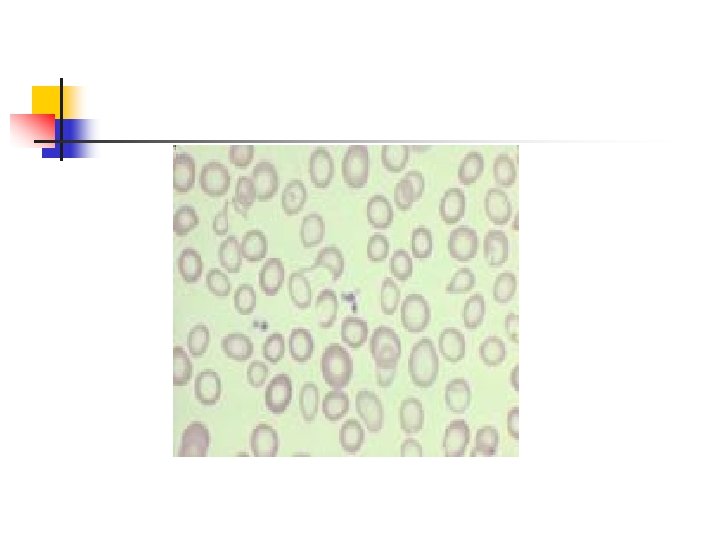
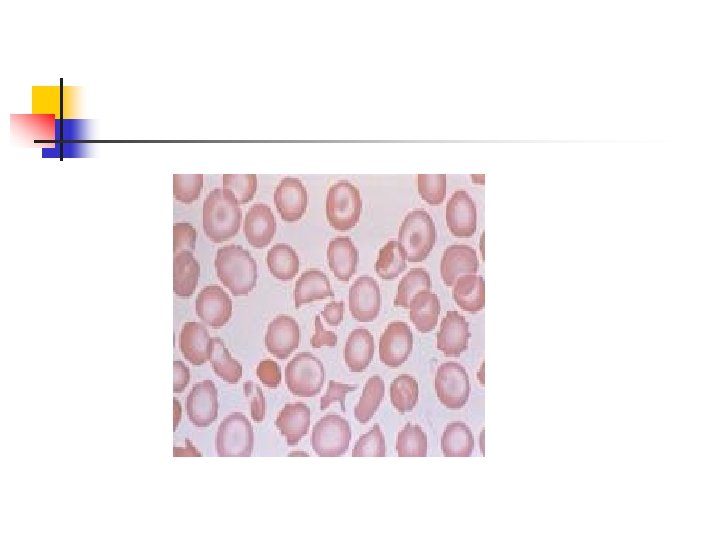

Thalassaemia Definition n Group of hereditary disorders characterized
































- Slides: 32

Thalassaemia

Definition n Group of hereditary disorders characterized by a genetic deficiency in the synthesis of alpha or beta-globin chains

Historical background Beta thalassemia n n First described by Cooley and Lee in 1925. Mediteranian ancestry. n n Cooley's Anemia Mediteranian Anemia

Review of hemoglobin structure n In the adult ……three hemoglobin types n n n Hgb A…. 2 alpha & 2 beta chains - 95% of total Hgb A 2… 2 alpha & 2 delta chains - 3% of total Hgb F… 2 alpha & 2 gamma chains - 2% of total

Geografical Distribution n Mediterranean Italians Greeks, Arabian Peninsula, Iran, Africa, Southeast Asia southern China.

Indian/Pakistani origin n b-thalassemia trait n n 1 -15% α-thalassemia n 5– 10%

Genetics n Autosomal Recessive

Pathophysiology: n n Imbalance between the normal rate of alpha-chain production and the impaired rate of beta-chain production. Beta+ thalassemia n n Decreased beta-chain production Beta -0 thalassemia n Absent beta-chain production.

n n n less hemoglobin deposited in each RBC…. hypochromasia. The Hb deficiency ……. microcytosis. In Silent carrier state both Hb level and RBC indices remain normal.

Elevated A 2 Hb n n n delta chains that, by pairing with the alpha chains, produce Hb A 2 (about 2. 5 -3% of the total Hb). due to the increased utilization of delta chains by the excessive free alpha chains The delta gene has physiological limitation in its ability to produce adequate delta chains

Hemolysis in thalassemia n n n The remaining alpha chains precipitate in the cells reacting with cell membranes intervening with normal cell division acting as foreign bodies destruction of RBCs. Ineffective erythropoiesis Erythroid hyperplasia and extramedullary hematopoiesis.

TYPES OF BETA THALASSEMIA 1 -Hetrozygous States Thalassemia Minor 2 -Homozygous States Thalassemia Intermedia Thalassemia Major

Clinical feature Thalassemia Major n Age of presentation n n n 6 -12 months of life Fatigue, poor appetite, and lethargy Abdominal distention Failure to gain weight History of consanguinity Similar history in family

Systemic review n n n Polyuria & polydipsia Jaundice Constipation, lethargy Breathlessness on exertion, edema Tetany, fits

Examination n n n Pallor Jaundice Height & weight Greenish yellow hue pigmentation Typical facies (maxillary hyperplasia, flat nasal bridge, frontal bossing Hepatosplenomegaly


Thalassemia Minor n n asymptomatic mild microcytic anemia Detected through routine blood tests

Investigations n n Blood count, ESR, RBC morphology & Retic Count Hb Electrophoresis Serum Ferritin Chest X-Rays

Hemoglobin Electrophoresis n Thalassemia Minor n n Thalassemia Intermedia n n Decreased Hb. A 1 Elevated Hb. A 2 upto 10% (normal 2. 5%) Elevated Hb. F upto 7% (normal <2. 0%) Decreased Hb. A 1 (20 -40%) Hb. A 2 always elevated Hb. F is 60 -80% of total hemoglobin Thalassemia Major n n n Absent Ab. A 1 Elevated Hb. A 2 (>3%) Hb. F (>90% Hb. F may be 100%at birth)

Skull X-Rays

Management n General n n Counselling of parents Diet Tab folic acid Vaccination n Hepatitis B

Specific n Regular blood transfusion n n Super blood transfusion n n Keep Hb upto 10 gm% Keep Hb upto 12 gm% Packed cells transfusion n Three or four weekly n 15 to 20 ml/kg

Chelation Therapy n Desferoxamine n n n 20 -60 mg/kg Subcutaneously over 8 -12 hrs 5 -6 night /week Defriperone n n Oral chelator Alone has poor response and severe side effects

Other modalities n Splenectomy n n Hypersplenisim Increased blood transfusion requirement Large Spleen Bone Marrow Transplantation n Definitive

Complications n Congestive heart failure n n n Transfusion reactions n n n Severe aneamia Cardiomyopathy Acute Late Blood borne infections

n Hemosidrosis n n Endocrinopathy n Diabetes mellitus n Hypoparathyroidism n Hypogonadism Chronic liver disease

n Side effect of chelation therapy n n Retinopathy Deafness Metabolic bone disease Agranulocytosis

PROGNOSIS n n n Increase quality of life with proper management Death due to congestive heart failure is common Bone marrow transplantation is curative
